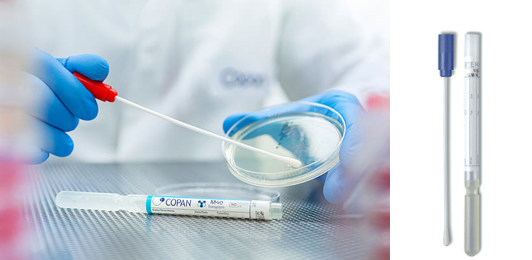

Clinical
>
Collection & Transport Devices

eNAT® System for Molecular Specimens
Copan eNAT® System is intended to collect, transport, and preserve microbial and human nucleic acids to be analyzed by amplification techniques. With its rapid analysis and inactivation features, eNAT® is the ready-to-use device to quickly homogenize your sample, for a high-quality, unbiased nucleic acid yield, and fast turnaround time from the sample to the response.

eSwab®
eSwab® – Copan’s Liquid Amies Elution Swab – collection and transport system is our multipurpose media intended for the collection and transport of clinical specimens containing aerobes, anaerobes, fastidious bacteria, viruses and Chlamydia.

FecalSwab™
FecalSwab™ is intended to collect fecal specimens and preserve enteric pathogenic bacteria’s viability to be processed using standard clinical laboratory operating procedures for culture.

LBM® Broths
Along with microbiology collection, preservation and transport systems, Copan’s portfolio includes a full range of enrichment and selective broths.

MSwab®
Dual Purpose Medium for collection, transport and preservation of bacteria and viruses.

SRK®
Our Swab Rinse Kits line includes comprehensive tailor-made collection and devices for the detection of environmental microbial contamination in a broad range of environments, such as food production, pharmaceutical sites, and hospital wards. Inspectors and Quality Assurance personnel can use SRK® products for routine surface monitoring within manufacturing areas, hospital surfaces, and equipment.

Transystem™
Our Transystem™ family comprises different media for the efficient and safe transport of many bacterial strains. Choose between liquid or solid Amies and Stuart medium for aerobic culture, rapid antigen, and molecular testing; opt for gel Cary-Blair medium – with or without charcoal – for aerobic and anaerobic cultures.
M40 Transystem™
M40 Transystem™ are compliant with the CLSI M40-A standard and are available in Liquid Amies, Liquid Stuart and Amies Agar Gel with or without charcoal formulas. M40 Transystem™ applicator swabs are manufactured using a unique bio-treatment process together with a careful selection of glue and binding agents maximizing organism survival on the swab, and subsequent release into the test platform or culture media.

UTM®
Copan Universal Transport Medium® (UTM®) system is intended for the collection, transport, and preservation of clinical specimens containing Viruses, Chlamydia, Mycoplasma, and Ureaplasma.

cf-DNA & cF-RNA Preservative Tubes
For Whole Blood Collection and Preservation of Cell-Free Circulating DNA and RNA. For research use only and not intended for in vitro diagnostics.

cf-DNA & cF-RNA Preservative Tubes Dx
For Whole Blood Collection and Preservation of Cell-Free Circulating DNA and RNA. Intended for in vitro diagnostics use.

Urine Collection and Preservation Devices
The components of the Urine Preservative allow samples to be stored for over 2 years at room temperature with no detected degradation of urine DNA, RNA or proteins. For research use only and not intended for in vitro diagnostics. (5cc/15cc/50cc/Single Dose Preservative/120cc)

Saliva DNA Collection and Preservation Devices Dx
Intended for in vitro diagnostic use.

Saliva DNA Collection and Preservation Devices
For simple and non-invasive saliva collection and preservation of DNA in saliva samples at ambient temperature. For research use only and not intended for in vitro diagnostics.

Saliva RNA Collection and Preservation Devices
For simple and non-invasive saliva collection and preservation of RNA in saliva samples at ambient temperature. For research use only and not intended for in vitro diagnostics.

Saliva Exosome Collection and Preservation Kit
For the preservation of exosomes in fresh saliva specimens. For research use only and not intended for in vitro diagnostics.

Saliva Exosome Collection and Preservation Kit
For the preservation of exosomes in fresh saliva specimens. For research use only and not intended for in vitro diagnostics.

Saliva RNA Collection and Preservation Devices Dx
Preserve High Quality RNA, including Viral RNA, for up to 2 Months. Intended for in vitro diagnostic use.

Stool Nucleic Acid Collection and Preservation Tubes
A rapid and simple method for the collection, preservation and room temperature shipping of stool samples. For research use only and not intended for in vitro diagnostics.

Fecal DNA Collection and Preservation Mini Tubes
A rapid and simple method for the preservation of DNA from fresh fecal samples. For research use only and not intended for in vitro diagnostics.

Stool Nucleic Acid Collection and Preservation Devices Dx
For the collection and preservation of stool samples at ambient temperatures. Intended for in vitro diagnostic use.

Stool Nucleic Acid Collection and Preservation System
All-in-one system for the rapid and simple collection, preservation, and room temperature storage and shipping of stool samples. For research use only and not intended for in vitro diagnostics.

Fecal Swab Collection and Preservation System
A rapid and simple method for the collection, preservation and shipping of stool samples. For research use only and not intended for in vitro diagnostics.

Milk DNA Preservation and Isolation Kit
A rapid all-in-one procedure for the preservation and isolation of milk DNA at ambient temperatures.
